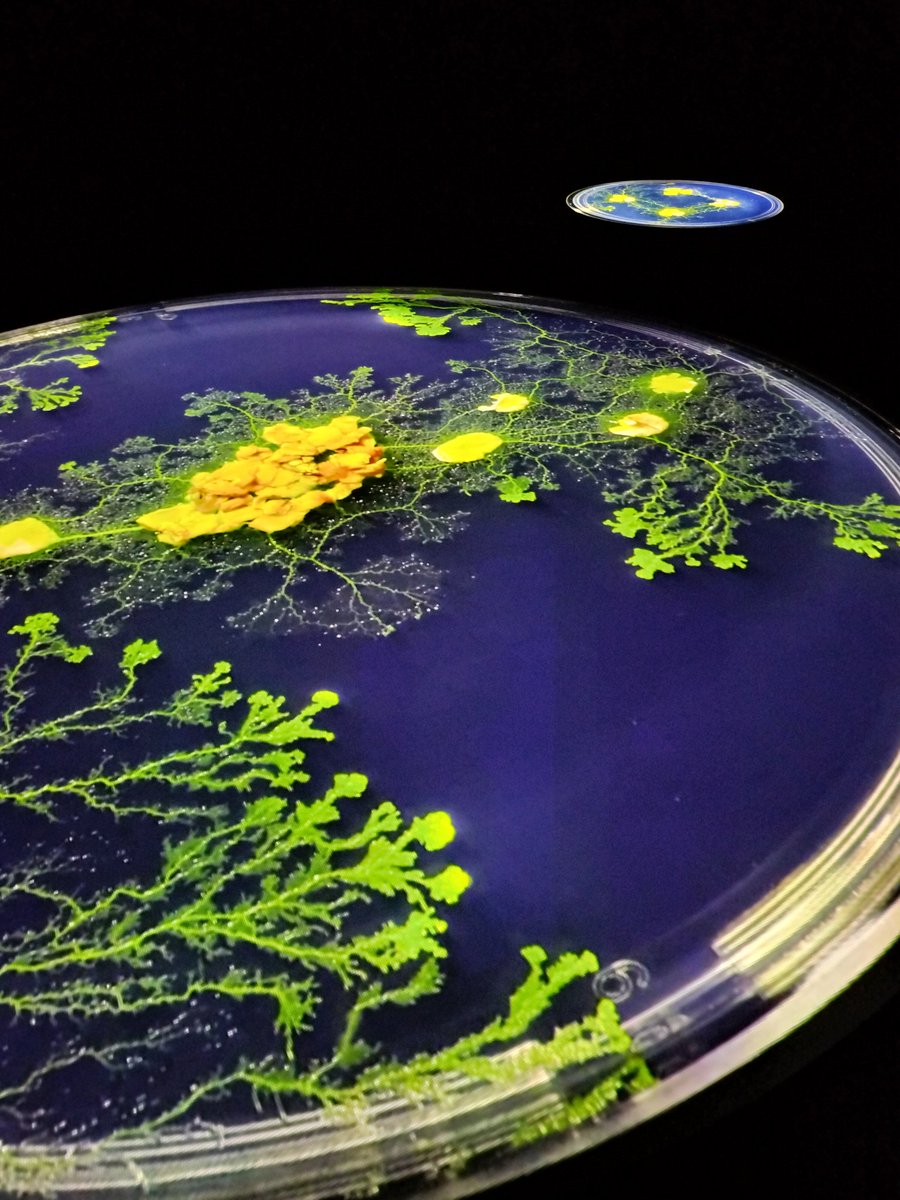
5BpXDJk1DRRNTcz's tweet image. 弱法師…すごく面白かったです
細菌を観た後だったからな
アングラっぽい映画とかお好な方に本当にオススメですっっ
無料なんて信じられない(´Д⊂ヽ♥
#SCARTS #札幌文化芸術交流センター #市原佐都子　さん

#scarts search results
#創作キャラバン 始まりました 🎊 #札幌文化芸術交流センター #SCARTS 中央区北1条西1丁目 10時-19時 昨日は野外で暑さに負けそうだったけど、今日は室内で快適♪ 最近、出したばかりの #グリーンゴールデンマイカ がメチャ綺麗✨ 遊びに来てね🙋♂️


弱法師…すごく面白かったです 細菌を観た後だったからな アングラっぽい映画とかお好な方に本当にオススメですっっ 無料なんて信じられない(´Д⊂ヽ♥ #SCARTS #札幌文化芸術交流センター #市原佐都子 さん




人の動きで色、光、音など映像が変わるデジタルアート。 SCARTSで開催中の、ソニーグループのクリエイティブセンターが手がける「INTO SIGHT」。 透明のガラス壁面、光を反射する天井に囲まれ、まるで宇宙空間にいるような、不思議な没入感を体験できます。 #siaf2024 #scarts
#札幌文化交流センター で出店中🎊 #彩の和 14㈯~18時 中央区北1条西1丁目 #SCARTS での出店はいつぶりだろうか?って程久しぶり♪ 遊びに来てね☀️🙋♂️ 出店終了後、21時~三時間はminneでクーポンが出るようです❗ minne.com/@shin-acc



今日は3,500円以上のお買い物で400円OFFになります! 今年も「もうすぐバレンタインかぁ」なんて思うこの季節。minneにも、バレンタインにぴったりのスイーツがたくさん集まっています!大切な人へのプレゼントや、自分へのご褒美にいかがですか? クーポン詳細▶minne.com/infos/3061?utm…

渡沢陽人、火學お七にて「暦屋」を演じます! 火を点けたのは誰なのか、火に魅せられたのは… 今回はなかなかお目にかかれない円形劇場の公演です! アキのマリーからの成長を是非観てください! #風蝕異人街 #火學お七 #SCARTS 予約フォーム quartet-online.net/ticket/fushoku…





明日17日(土) STEAM STUDY DAY in #SCARTS 札幌文化芸術交流館 開催★ラスト告知★ SIAF2024エデュケーションWeek ドローイング 鑑賞 数学 マイコン プログラミング サウナ!? #SIAF2024 告知 2024.siaf.jp/event/53/ 特設サイト sites.google.com/view/siafsteam… 申し込みフォーム forms.gle/KBSWsV5u59TWcG…

7月23日(日)はここに来てね! ボランティアスタッフ若干名どなたか? aurora-dance.jp/eventhokkaido.… #オーロラ #札幌市民交流センター #SCARTS #adpro #オーロラダンス

A fancy pinkish purple. Come take a look at my Sapporo show. #scarts 5/12-5/14 #purplediamond #パプルダイヤ

札幌市民交流プラザにて26日まで開催中、『柴田あゆみ かみがみの森』を見てきました。 1枚1枚、重なったレイヤーと明暗が織り成す世界。1mmよりも小さい穴の一つ一つにまで息吹が宿ってる……。ため息が出そうでした。 #柴田あゆみ #かみがみの森 #scarts #札幌市民交流プラザ




弱法師…すごく面白かったです 細菌を観た後だったからな アングラっぽい映画とかお好な方に本当にオススメですっっ 無料なんて信じられない(´Д⊂ヽ♥ #SCARTS #札幌文化芸術交流センター #市原佐都子 さん

Excited to welcome the SC Governor’s School for the Arts & Humanities to our middle school today! 🎭🎶📚 Inspiring creativity, excellence, and big dreams in our students—what an honor! #LetsGrowTogether #SCArts #FutureCreators @OconeeSC_school @GovieAlumOffice

北海道キャラモデルコンベンション開催されます。 4月11日(土曜)、いつもの #さっぽろ創世スクエア #札幌文化芸術交流センター #SCARTS 詳細や参加募集要項等は今後発表されます。 ご参加、ご来場おまちしております。 今年も楽しみましょう~ #北海道キャラモデルコンベンション @hokkaidocharamo
モデラーの皆様、今年もよろしくお願いします。 さて、第1回北海道キャラモデルコンベンションが今年の4月11日(土)に開催されます。 この度、新ポスターが完成致しましたのでお知らせいたします。公式Webよりダウンロードできますのでぜひ告知等でお使いください!hokkaidocharamokei.web.fc2.com

音の建築彫刻 — 交差するBachとアンビエント 音は空間を彫刻し、身体は共鳴体となる。 バロック×アンビエント×能×映像。 札幌・SCARTSで12/20-21開催。 🎟 ¥4,000|自由席 詳細👇 cai-net.jp/information/%e… #音の建築彫刻 #SCARTS #CrossingBachAndAmbient #ContemporaryArt
この作品は、公開情報によれば『蘭芳公司』という台湾を舞台にした劇映画を作るためのリサーチも兼ねたドキュメンタリーだそうです。 この作品を観て特に問題と感じたのは、この作品の企画・製作が #愛知県美術館 #札幌文化芸術交流センター #SCARTS であることもあります kuzoku.com/news/3651/
🐰🐻文化芸術関係のお悩みは、#SCARTS へ 対面相談サービス sapporo-community-plaza.jp/scarts_service… 🐯「もっと集客を増やしたいけど、広報どうしたらいい?」 🦖「作品を発表したい!」 🐼「助成金のことおしえて!」 などなど、 事前予約制で、ご相談は無料。 どうぞお気軽にお申込みください。 #活動支援

「影は実像を映す」 札幌の美術ユニット「故郷2nd」8日から個展 :北海道新聞デジタル hokkaido-np.co.jp/article/122055… #札幌 #故郷2nd #SCARTS #影広場
丹治康人さんのレクチャーに参加しました。 舞台の裏側を少し学べたのと同時に、演劇への関心が少し戻ってきた気がします。 そんな私の無茶ぶりな質問にも真摯に答えていただきました。 まずは書きかけの脚本に手を付けようかなと思います…! #SCARTS
#SCARTS ラーニングプログラム 「おしえて!アートのおしごと【演劇編】~"演出助手"って知ってる?~」 演出助手チーム『SPM』代表の丹治泰人さんを講師にむかえ、演出助手の「おしごと」や、これまでのエピソードなどをたっぷり伺います。 詳細・参加申込ℹ️ sapporo-community-plaza.jp/event_scarts.p…

🎼大学連携コンサート 北海道教育大学岩見沢校 「退廃の烙印をおされた作曲家たち」 #北海道教育大学岩見沢校 の学生5名によるミニコンサートです。 次世代を担う若き音楽家たちの熱い演奏をぜひお楽しみください。 🎼詳細・お申込み(#SCARTS HP) sapporo-community-plaza.jp/event_scarts.p…

#SCARTS 札幌文化芸術交流センター(SCARTS)では、2026年に向けて、文化芸術を通したまちづくりのための、企画を募集しています。詳しくはSCARTSまで。


SCARTS企画公募2025 Sumitto Art―望月澄人回顧展― sapporo-community-plaza.jp/event_scarts.p… 日時:2025年5月31日(土)~ 6月8日(日) 11:00 ~ 19:00 会場:SCARTSコート 入場無料 #scarts #scarts企画公募 #sumittoart #望月澄人 #横須賀令子



#創作キャラバン 始まりました 🎊 #札幌文化芸術交流センター #SCARTS 中央区北1条西1丁目 10時-19時 昨日は野外で暑さに負けそうだったけど、今日は室内で快適♪ 最近、出したばかりの #グリーンゴールデンマイカ がメチャ綺麗✨ 遊びに来てね🙋♂️


#札幌文化交流センター で出店中🎊 #彩の和 14㈯~18時 中央区北1条西1丁目 #SCARTS での出店はいつぶりだろうか?って程久しぶり♪ 遊びに来てね☀️🙋♂️ 出店終了後、21時~三時間はminneでクーポンが出るようです❗ minne.com/@shin-acc



今日は3,500円以上のお買い物で400円OFFになります! 今年も「もうすぐバレンタインかぁ」なんて思うこの季節。minneにも、バレンタインにぴったりのスイーツがたくさん集まっています!大切な人へのプレゼントや、自分へのご褒美にいかがですか? クーポン詳細▶minne.com/infos/3061?utm…

7月23日(日)はここに来てね! ボランティアスタッフ若干名どなたか? aurora-dance.jp/eventhokkaido.… #オーロラ #札幌市民交流センター #SCARTS #adpro #オーロラダンス

渡沢陽人、火學お七にて「暦屋」を演じます! 火を点けたのは誰なのか、火に魅せられたのは… 今回はなかなかお目にかかれない円形劇場の公演です! アキのマリーからの成長を是非観てください! #風蝕異人街 #火學お七 #SCARTS 予約フォーム quartet-online.net/ticket/fushoku…





A fancy pinkish purple. Come take a look at my Sapporo show. #scarts 5/12-5/14 #purplediamond #パプルダイヤ

札幌市民交流プラザにて26日まで開催中、『柴田あゆみ かみがみの森』を見てきました。 1枚1枚、重なったレイヤーと明暗が織り成す世界。1mmよりも小さい穴の一つ一つにまで息吹が宿ってる……。ため息が出そうでした。 #柴田あゆみ #かみがみの森 #scarts #札幌市民交流プラザ




昨日はこちらに参加していました。 中村会子がツアー中のため、EnsembleViaメンバーが代理で報告。 今年は演奏会の動画を流せて雰囲気を伝えられました。クラシック確立以前のヨーロッパ音楽なのでやってる本人達も古文書の謎解きしながらあれこれ演ってます。 #中ヨ #SCARTS

明日17日(土) STEAM STUDY DAY in #SCARTS 札幌文化芸術交流館 開催★ラスト告知★ SIAF2024エデュケーションWeek ドローイング 鑑賞 数学 マイコン プログラミング サウナ!? #SIAF2024 告知 2024.siaf.jp/event/53/ 特設サイト sites.google.com/view/siafsteam… 申し込みフォーム forms.gle/KBSWsV5u59TWcG…

Something went wrong.
Something went wrong.
United States Trends
- 1. Real Madrid N/A
- 2. Denzel N/A
- 3. Arbeloa N/A
- 4. Patty Hearst N/A
- 5. Shingles N/A
- 6. Spain N/A
- 7. Rudiger N/A
- 8. Pam Grier N/A
- 9. Connor Murphy N/A
- 10. #RHONY N/A
- 11. Will Cain N/A
- 12. Xabi N/A
- 13. Tyus Jones N/A
- 14. Matt Walsh N/A
- 15. NATO N/A
- 16. General Keane N/A
- 17. Penta N/A
- 18. #IranIsraelWar N/A
- 19. Nancy Mace N/A
- 20. Actress N/A





































![CAICAI02's tweet card. 詳しくはこちらからhttps://cai-net.jp/?post_type=projects&p=7069&preview=true 公演日時 2025 年12 月20(土) 18: […]](https://pbs.twimg.com/card_img/2027538299481432064/Ke7m9Tc-?format=jpg&name=orig)








































![SCArtsTech's profile picture. Santa Cruz Arts & Technology Festival [ https://t.co/M2W4N9cKws ] May 13-14 2016 Create Celebrate Innovate Collaborate for healthy sustainable community](https://pbs.twimg.com/profile_images/708914433620189184/O99FMyGX.jpg)













